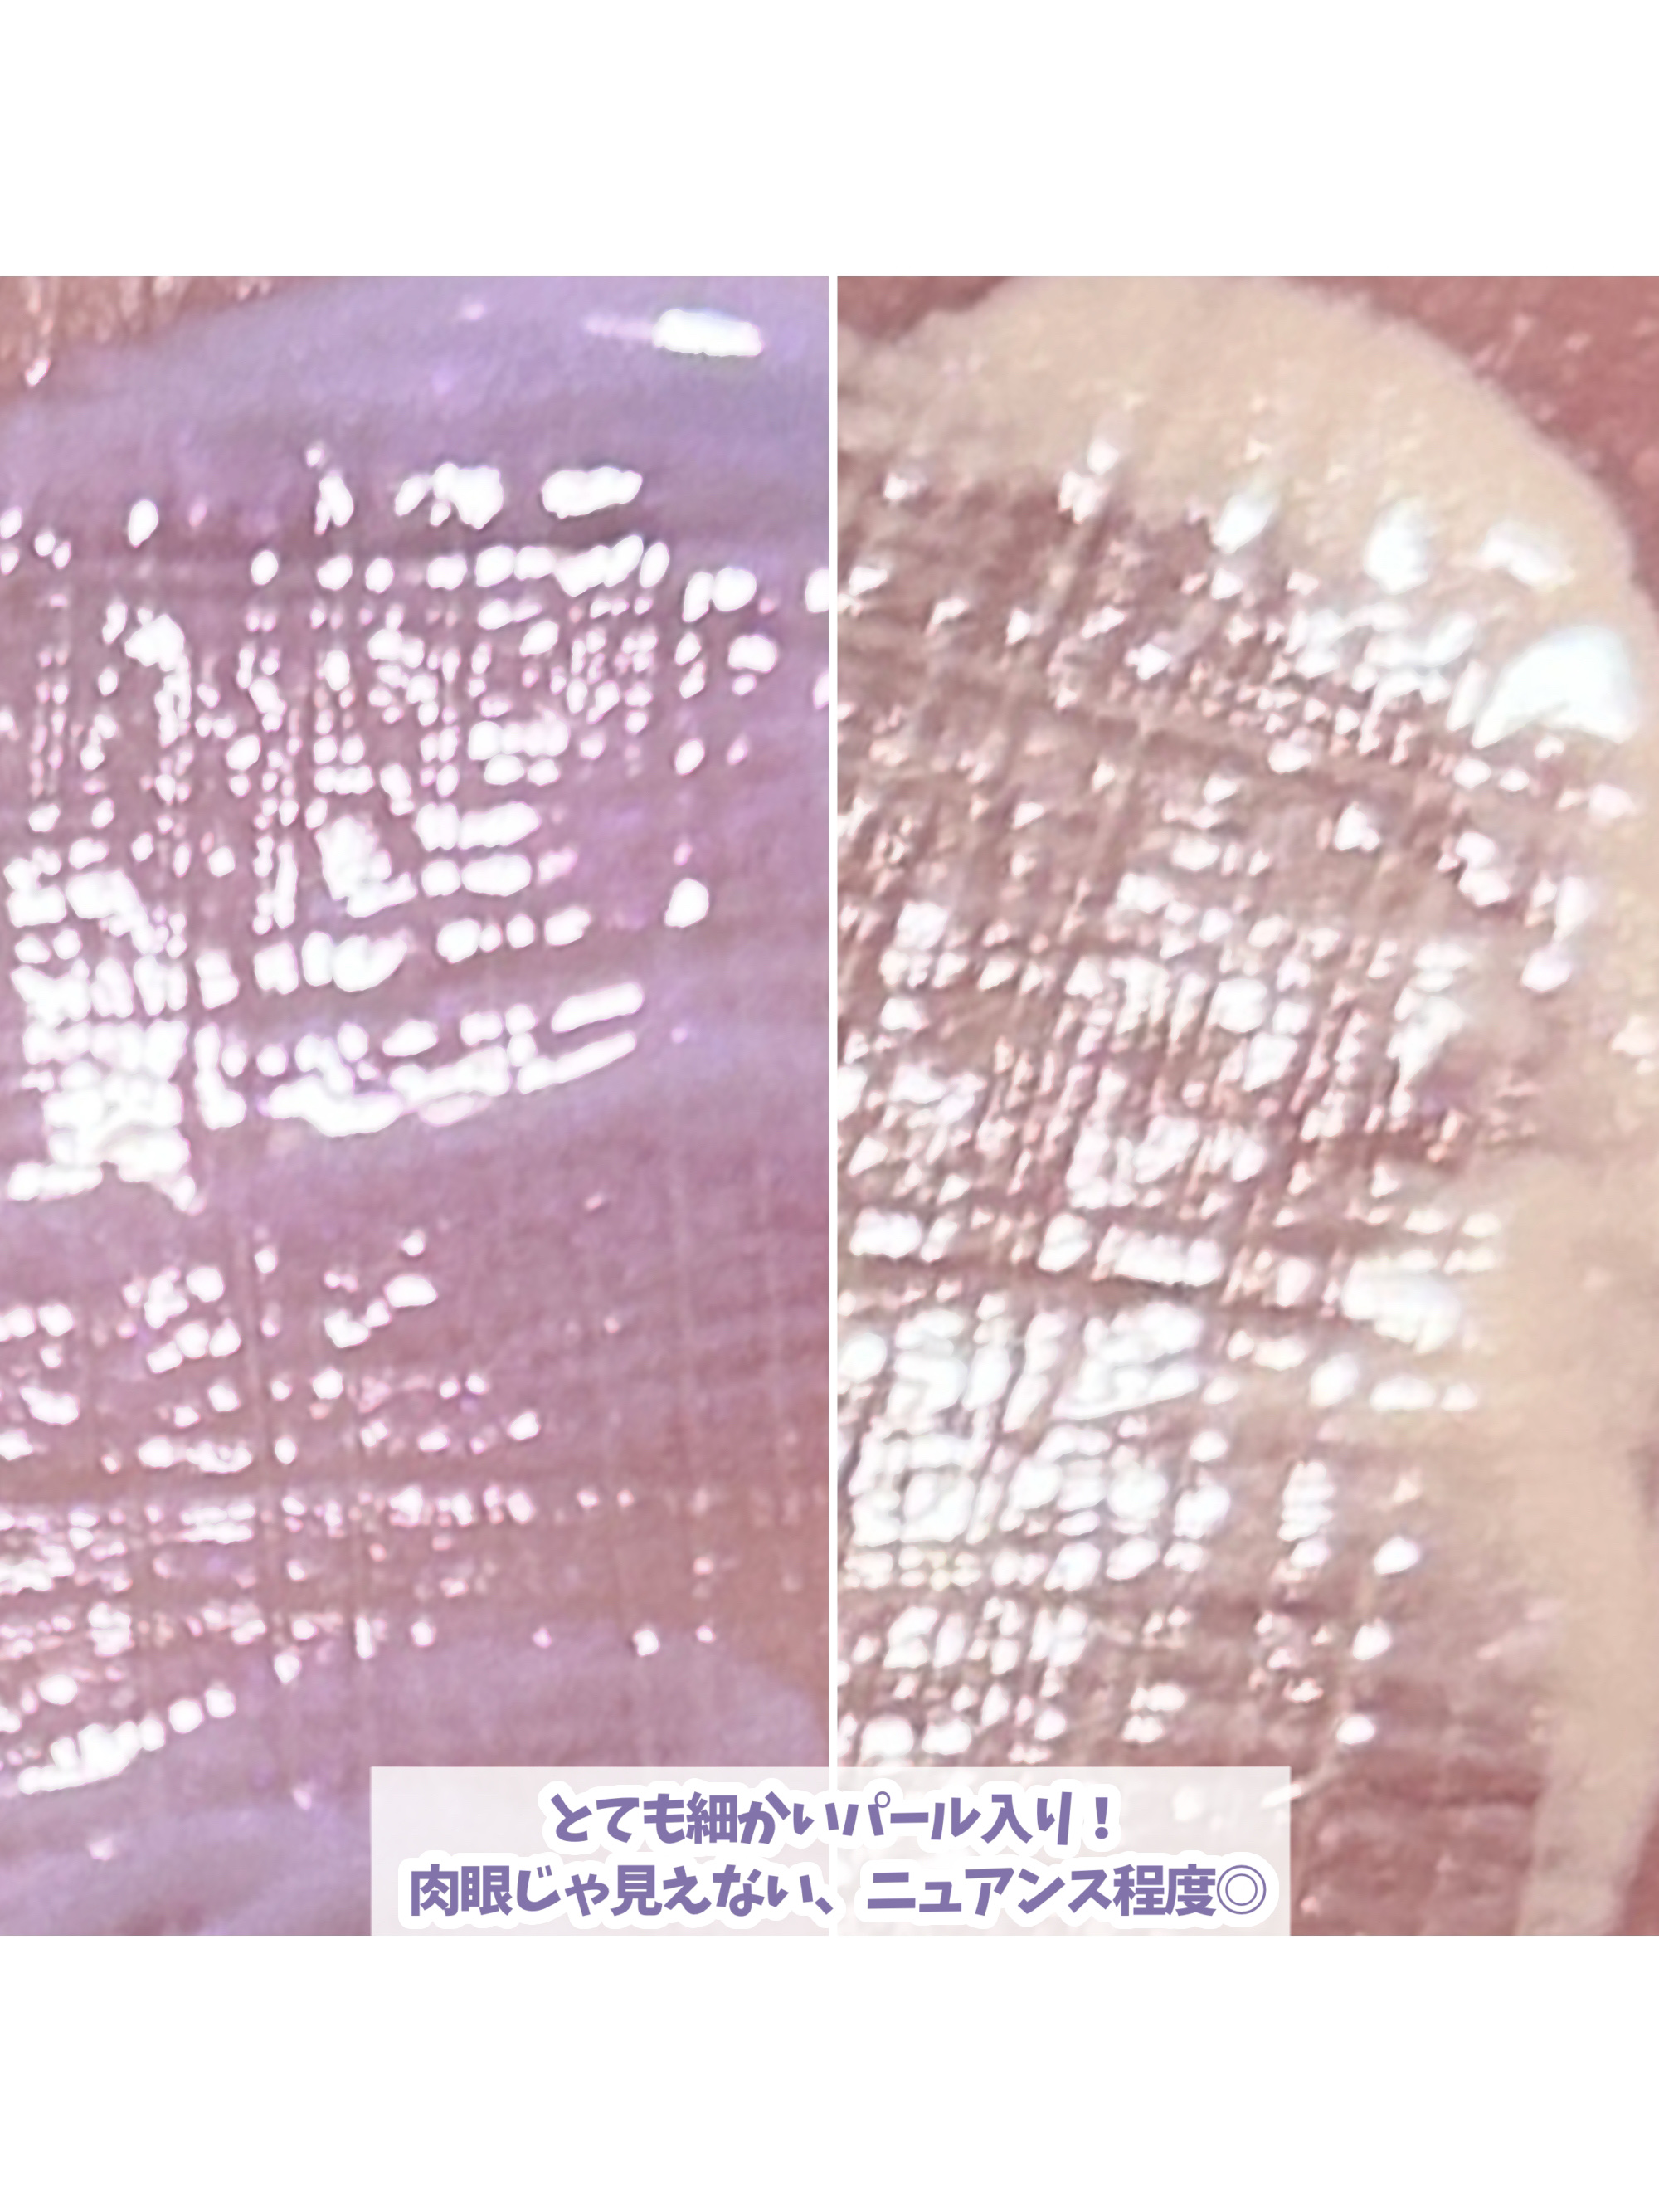
ケイト カラーコントロールアイベース/KATE/アイシャドウベースを使ったクチコミ（3枚目）

🌷KATEケイト カラーコントロールアイベース *EX-1しのばせラベンダーアイシャドウ見たまま発色アイシャドウベースまぶたの地の色をカラーでコントロールアイシャドウの色を見たまま発色へ⚪︎まぶたに伸ばしやすいリキッドタイプ⚪︎まぶたの肌のキ...
もっと見るおすすめアイテムKATE×アイシャドウベース
| 商品画像 | 商品情報 | 参考価格 | 評価 | ランキングIN | 特徴 | 商品リンク |
|---|---|---|---|---|---|---|
KATE ザ アイカラーベース | 715円 |
| アイシャドウベースランキング第15位 | クリームタイプのテクスチャー。 パールが含まれている為、ツヤ感のある仕上がりに🌟 | 詳細を見る | |
KATE ケイト カラーコントロールアイベース | 1,045円 |
| 使いやすいテクスチャーで、ささっと塗れます。 粉を重ねやすい、さらさらな仕上がりに。 | 詳細を見る | ||
KATE アイシャドウプライマー | 1,044円生産終了 |
| クリームタイプのアイシャドウに近い質感で、ラメもザクザクなのでこれだけでも十分な存在感が! | 詳細を見る |
アイシャドウベースランキング
| 商品画像 | 商品情報 | 参考価格 | 評価 | ランキングIN | 特徴 | 商品リンク |
|---|---|---|---|---|---|---|
TOM FORD BEAUTY エモーションプルーフ アイ プライマー | 5,390円 |
| アイシャドウベースランキング第1位 | このプライマーはだいぶテクスチャがなめらかなのでかなり塗りやすかったです | 詳細を見る | |
キャンメイク ラスティングマルチアイベース WP | 550円 |
| アイシャドウベースランキング第2位 | アイシャドウがピタッと密着して、使用していない時と比べるととても落ちにくい しっかり色味を発色させてくれる | 詳細を見る | |
M・A・C M·A·C プレップ プライム 24 アワー エクステンド アイ ベース | 4,180円 |
| アイシャドウベースランキング第3位 | のせて伸ばした途端、 サラッサラになるんです。アイメイクの見栄えが、より美しくなります! | 詳細を見る | |
キャンメイク アイシャドウベース | 550円 |
| アイシャドウベースランキング第4位 | まぶたに塗ると、サラサラとパウダーのような質感に!密着してモチもよくなる♪ | 詳細を見る | |
excel フィットアイベース | 1,045円 |
| アイシャドウベースランキング第6位 | 明るいベージュ。 くすみがとび、自然にトーンアップ。 なめらかでするする伸びる! | 詳細を見る | |
CEZANNE アイメイクベース | 638円 |
| アイシャドウベースランキング第5位 | 普段のアイシャドウの発色が変わった! まるで別物…乳白色の液でマットな質感 柔らかいチップで塗りやすい | 詳細を見る | |
pdc ピメル パーフェクトアイベース | 1,320円 |
| アイシャドウベースランキング第7位 | パール配合のベージュ系カラーで、目元をほんのり明るく見せてくれるとともに、乾いた後はサラッとした使用感で他のメイクの邪魔をしない | 詳細を見る | |
NARS スマッジプルーフ アイシャドーベース | 3,740円 |
| アイシャドウベースランキング第8位 | 発色もあがる♡使うと使わないじゃ発色の仕方も夕方までの色の残り方も全然違う! | 詳細を見る | |
excel アイシャドウベース | 1,044円 |
| アイシャドウベースランキング第9位 | まぶたの色を均一に。テクスチャーがやわらかく薄く伸ばしやすい♪保湿効果もバッチリ♡ | 詳細を見る | |
無印良品 アイカラーベース | 590円 |
| アイシャドウベースランキング第10位 | クリームだから塗りやすいし塗った後のパウダータイプのアイシャドウも塗りやすくなってる。 | 詳細を見る |
えみいさんの人気クチコミ
ヌーディなリップが欲しくて買ってみた 肌馴染みが良くてブルベでも使いやすかったよ スモークドベージュより少し赤みがあるタイプ 私はスモークドベージュの方が好みだった マットリップだからチークとして使ったりアイシャドウの代わりに使ったりもしてる 統一感が出てイイ感じ♪
もっと見る
73
3
- 2025.02.19
深みが出るから秋冬のこっくりしたメイクに…と言いつつ夏も使ってたけど。使いやすくてついつい手が伸びてしまうカラーです 白みピンクが勢揃い!ブラウンカラーは柔らかくて使いやすいです。ラメもすごく綺麗 私はミューズモーメント推し☆
もっと見る
68
2
- 2025.02.09
明るすぎたリップに重ねるとトーンが落ちるから使いやすくなる イエベカラーのリップに重ねると青みが追加されるから2通り楽しめちゃう♪ プランピング効果はよくわからないけどスースーする感じが好きメガ割で他の色も追加購入する予定♡
もっと見る
67
0
- 2025.02.24
花粉で肌荒れがひどくて💦 目の周りが痒くてプツプツができちゃって困りに困って使ってみました 化粧水はサラサラタイプでどんどん入っていく感じで使いやすかった お陰様で肌荒れも落ち着きましたので花粉の時期に合わせてまたリピしまーす♡
もっと見る
67
1
- 2025.02.05
青みをプラスし透明感アップ♪ アイシャドウの色を見たまま発色へ ポンポン塗ったらすぐサラサラ すごく紫が残るわけではなく、くすみが飛ぶ感じ 淡い色のアイシャドウもしっかり発色する こりゃイイかも✨️
もっと見る
65
1
- 2025.02.10
朝に嬉しい泡立てなくていいジェル洗顔 どうしても、泡立てるのが面倒で… とってもぷるっぷる♡のジェルで粒子の細かいスクラブが汚れを落としてくれる感じ 洗い上がりはツルツル✨️しっとりしていて乾燥も感じませんでした
もっと見る
63
1
- 2025.02.07
商品詳細情報KATE ケイト カラーコントロールアイベース
- ブランド名
- KATE(ケイト)
- 容量・参考価格
- 生産終了
- 取扱店舗
- 近くのKATE取扱店舗はこちら
- バリエーション
- EX-1 しのばせラベンダー
- EX-2 なじませレモン
- EX-3 あかぬけピーチ
- EX-4 そこあげミルク
- 商品説明
- 数量限定発売 2024/12/14~アイシャドウベース3色が再発売。 さらに、ベージュ系アイシャドウにおすすめの新色も登場! 1 揮発成分の多い処方を採用 密着力を高め、肌のキメを整えることで発色アップ 2 保湿成分配合(ヒアルロン酸・水溶性コラーゲン) 3 ベタつかない、サラッと仕上がり まぶたに伸ばしやすいリキッドタイプ×チップ形状
- メーカー名
- カネボウ化粧品
- 発売日
- 2024/1/20(最新発売日: 2024/12/14)
- 成分
- <EX-1 しのばせラベンダー> 水、フェニルトリメチコン、メチルトリメチコン、BG、シリカ、イソステアリン酸ソルビタン、グリセリン、水添ポリデセン、ジカプリル酸PG、水添ポリイソブテン、ダイマージリノール酸(フィトステリル/イソステアリル/セチル/ステアリル/ベヘニル)、マルチトール、トリベヘニン、DPG、シア脂、ジメチコン、ジステアルジモニウムヘクトライト、トコフェロール、水添レシチン、ヒアルロン酸Na、ステアロイルグルタミン酸2Na、ミリスチン酸亜鉛、含水シリカ、水酸化Al、水溶性コラーゲン、フェノキシエタノール、メチルパラベン、デヒドロ酢酸Na、酸化チタン、タルク、マイカ、水酸化クロム、グンジョウ、酸化スズ、赤226 <EX-2 なじませレモン> 水、フェニルトリメチコン、メチルトリメチコン、BG、シリカ、イソステアリン酸ソルビタン、グリセリン、水添ポリデセン、ジカプリル酸PG、水添ポリイソブテン、ダイマージリノール酸(フィトステリル/イソステアリル/セチル/ステアリル/ベヘニル)、マルチトール、トリベヘニン、DPG、シア脂、ジメチコン、ジステアルジモニウムヘクトライト、トコフェロール、水添レシチン、ヒアルロン酸Na、含水シリカ、水溶性コラーゲン、フェノキシエタノール、デヒドロ酢酸Na、ソルビン酸、メチルパラベン、酸化チタン、タルク、マイカ、酸化鉄、酸化スズ <EX-3 あかぬけピーチ> 水、フェニルトリメチコン、メチルトリメチコン、BG、シリカ、イソステアリン酸ソルビタン、グリセリン、水添ポリデセン、ジカプリル酸PG、水添ポリイソブテン、ダイマージリノール酸(フィトステリル/イソステアリル/セチル/ステアリル/ベヘニル)、マルチトール、トリベヘニン、DPG、アルミナ、シア脂、ジメチコン、ジステアルジモニウムヘクトライト、トコフェロール、水添レシチン、ヒアルロン酸Na、含水シリカ、水溶性コラーゲン、フェノキシエタノール、デヒドロ酢酸Na、ソルビン酸、メチルパラベン、酸化チタン、タルク、マイカ、酸化鉄、酸化スズ、水酸化クロム、赤226 <EX-4 そこあげミルク> 水、フェニルトリメチコン、メチルトリメチコン、BG、シリカ、イソステアリン酸ソルビタン、グリセリン、水添ポリデセン、ジカプリル酸PG、水添ポリイソブテン、ダイマージリノール酸(フィトステリル/イソステアリル/セチル/ステアリル/ベヘニル)、マルチトール、トリベヘニン、DPG、シア脂、ジメチコン、ジステアルジモニウムヘクトライト、トコフェロール、水添レシチン、ヒアルロン酸Na、含水シリカ、水溶性コラーゲン、フェノキシエタノール、デヒドロ酢酸Na、メチルパラベン、ソルビン酸、タルク、マイカ、酸化チタン、酸化鉄
![LIPS[リップス] - コスメのクチコミ検索アプリ](https://cdn.lipscosme.com/assets/lips_logo_full_2022-bc7b4bc9dd66035bc5696b0d16bc3d38a7be357186656c039e68cc4cf21ae675.png)

コメント